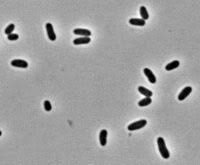
Klambt y los chicharos (1966)

-
En 1729, Michelli observó que las partículas de polvo que eran tomadas a partir de un hongo y depositadas en rebanadas de melón recién cortadas, reproducían a menudo la misma clase de hongo.
-
-
En 1743, fueron reportados por Needham los primeros nematodos filoparásitos al encontrarlos en el interior de las agallas del trigo (granos).
-
-
 En 1755, Millet mezcló el polvo negro tomado de un trigo infectado por un carbón con las semillas de un trigo sano y observó que el carbón era mucho más abundante en las plantas producidas a partir del trigo infectado que en las semillas de trigo no espolvoreadas.
En 1755, Millet mezcló el polvo negro tomado de un trigo infectado por un carbón con las semillas de un trigo sano y observó que el carbón era mucho más abundante en las plantas producidas a partir del trigo infectado que en las semillas de trigo no espolvoreadas. -
En 1807, Prevost demostró de manera determinante que el carbón cubierto lo ocasiona un hongo; estudió las esporas del hongo, su producción y germinación.
-
En 1850, se observaron otros nematodos entre ellos los del bulbo y del tallo, los noduladores y formadores de quistesen las raíces.
-
En 1853, DeBary trabajó con hongos de la roya y del tizón y determinó de manera concluyente que éstos son la causa, y no el resultado, de la enfermedad de la planta.
-
 En 1876, Pasteur y Koch demostraron que la enfermedad del ántrax en los animales era ocasionada por una bacteria.
En 1876, Pasteur y Koch demostraron que la enfermedad del ántrax en los animales era ocasionada por una bacteria. -
-
En 1877, Chillón y colaboradores demostraron que la bacteria que produce la agalla de la corona transforma a las células vegetales normales en células tumorosas al introducir en ellas un plásmido, parte del cual se inserta el DNA de los cromosomas de las células vegetales.
-
 En 1878 fue introducida en Europa una enfermedad originada en los Estados Unidos, conocida como mildiu velloso de la vid, donde tuvo una rápida seminación y amenazó con destruir sus viñedos.
En 1878 fue introducida en Europa una enfermedad originada en los Estados Unidos, conocida como mildiu velloso de la vid, donde tuvo una rápida seminación y amenazó con destruir sus viñedos. -
En 1878, Burrill también demostró que una bacteria era la causa del tizón de fuego del peral y del manzano.
-
-
 En 1886, DeBary trabajando con las pudriciones de zanahorias y otras hortalizas producidas por el hongo Sclerolinia.
En 1886, DeBary trabajando con las pudriciones de zanahorias y otras hortalizas producidas por el hongo Sclerolinia. -
 En 1886, Mayer reprodujo la enfermedad del "mosaico del tabaco", al inyectar el jugo de las plantas de tabaco infectadas en otras sanas.
En 1886, Mayer reprodujo la enfermedad del "mosaico del tabaco", al inyectar el jugo de las plantas de tabaco infectadas en otras sanas. -
-
-
 A principios de 1900, aparecieron los primeros estudios sobre la herencia de la resistencia a las enfermedades.
A principios de 1900, aparecieron los primeros estudios sobre la herencia de la resistencia a las enfermedades. -
-
 En 1905, Biffen describió la herencia mendeliana de la resistencia de dos variedades de trigo y su progenie a una roya.
En 1905, Biffen describió la herencia mendeliana de la resistencia de dos variedades de trigo y su progenie a una roya. -
En 1905, Jones publicó la intervención de las enzimas citoliticas que producen las bacterias en varias pudriciones blandas de hortalizas.
-
En 1909, Orton, trabajando con los marchitamientos del algodón, de la sandía y del caupí producidos por Fusarium, diferenció entre los fenómenos de resistencia y escape a las enfermedades.
-
En 1909, Lafont observó protozoarios flagelados en las células productoras de látex de las plantas lactíferas de la familia de las Euforbiáceas.
-
-
En 1911, Barms demostró que existe variabilidad genética dentro de las especies de patógenos; es decir, existen diferentes razas de un mismo patógeno, las cuales están restringidas a ciertas variedades de una especie hospedante.
-
En 1875, 1883 y 1912, Brefeld hizo grandes contribuciones a la fitopatología al introducir y desarrollar técnicas modernas para el cultivo de microorganismos en cultivos puros.
-
En 1913, Rietun introdujo el tratamiento de las semillas con compuestos orgánicos de mercurio.
-
En 1931, Stabel descubrió que algunos flagelados que infectaban el floema de los cafetales eran los agentes que ocasionaban la formación anormal del floema y la marchitez de los árboles.
-
En 1913 a 1932, Cobb efectuó una serie de estudios sobre los fitoparásitos, contribuyó ampliamente en los aspectos de metodología, morfología y taxonomía de los nematodos.
-
 En 1934, Tisdale descubrió el primer fungicida de ditiocarbamatos (tuíram).
En 1934, Tisdale descubrió el primer fungicida de ditiocarbamatos (tuíram). -
En 1947, Mechan y Murphy demostraron que una especie del hongo Helmini hosporium, que sólo atacaba y producía un tizón en las avenas de la variedad Victoria.
-
En 1950, los antibióticos se utilizaron por vez primera para controlar las enfermedades de las plantas.
-
En 1956, Gierer y Schramm mostraron que la proteína podía separarse del virus y que el ácido nucleico llevaba la información genética.
-
Müller propuso en 1961 y Cruickshank confirmó y amplió en 1963 la tesis de que la resistencia a las enfermedades suele deberse a la fitoalexinas.
-
En 1966, Klambt y colaboradores, Helgeson y Leonard demostraron que la bacteria Corynebacter iumfascíans, que ocasiona la fasdadón de los chícharos.
-
En 1967, en Japón, Doi y sus colaboradores observaron cuerpos semejantes a las micoplasmas en el floema de las plantas infectadas por varias enfermedades transmitidas por chicharritas.
-
 En 1967, Ishiie y colaboradores demostraron que los síntomas y los corpúsculos semejantes a las micoplasmas desaparecían temporalmente cuando las plantas infectadas eran tratadas con antibióticos de tetraciclina.
En 1967, Ishiie y colaboradores demostraron que los síntomas y los corpúsculos semejantes a las micoplasmas desaparecían temporalmente cuando las plantas infectadas eran tratadas con antibióticos de tetraciclina. -
-
En 1971, Diener determinó que la enfermedad del tubérculo fusiforme de la papa era ocasionada por una pequeña molécula circular de RNA infeccioso de una sola cadena, a la que llamó viroide.
-
En 1972, New y Kerr introdujeron el primer método de control biológico (con fines comerciales) de una enfermedad bacteriana de las plantas (la agalla de la corona) mediante el uso de otra bacteria.
-
En 1972, Davis y sus colaboradores observaron, un microorganismo helicoidal y móvil asociado con la enfermedad del acha-parramiento del maíz, al que denominaron espiroplasma.
-
 En 1972, Windsor y Black observaron organismos parecidos a las rickettsias en el floema de plantas de trébol que habían sido infectadas por la enfermedad de la hoja redondeada.
En 1972, Windsor y Black observaron organismos parecidos a las rickettsias en el floema de plantas de trébol que habían sido infectadas por la enfermedad de la hoja redondeada. -
En 1973, se observaron organismos similares en la vid infectada por la enfermedad de Pierce, en los durazneros infectados por la enfermedad del durazno falso, y en otros.
-
 En 1976, se reportaron también flagelados asociados a varias enfermedades de los cocoteros y palmeras africanas en Sudamérica y en África.
En 1976, se reportaron también flagelados asociados a varias enfermedades de los cocoteros y palmeras africanas en Sudamérica y en África. -
En 1977, Drummond y colaboradores demostraron que el DNA Tincorporado es transcrito por las células de la planta hospedante.
-
En 1980, el virus del mosaico de la coliflor fue el primer virus fitopatógeno del que pudo determinarse la secuencia exacta de sus 8000 pares de bases.
-
 En 1982, se determinó la secuencia completa de bases del RNA de una sola cadena del virus del mosaico del tabaco.
En 1982, se determinó la secuencia completa de bases del RNA de una sola cadena del virus del mosaico del tabaco.
A list shows items. A timeline shows sequence.
Use Timetoast to make dates, milestones, and turning points easier to understand in a clear visual format. Timetoast is a timeline maker for work, school, research, and stories.